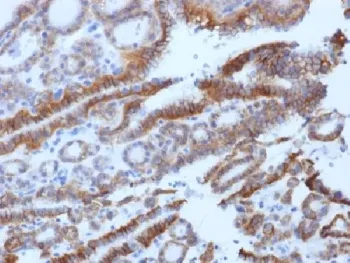
Thyroid Stimulating Hormone Receptor / TSHR Antibody (beta chain) - image 1

Thyroid Stimulating Hormone Receptor / TSHR Antibody (beta chain)
CAT:
800-V3432-20UG
Size:
20 µg
Price:
Ask
- Availability: 24/48H Stock Items & 2 to 6 Weeks non Stock Items.
- Dry Ice Shipment: No

Thyroid Stimulating Hormone Receptor / TSHR Antibody (beta chain)
Description:
Thyroid-stimulating hormone (TSH, also known as thyrotropin) is a glycoprotein involved in the control of thyroid structure and metabolism, which stimulates the release of the thyroid hormones. TSH is regulated by thyroid hormone (T3) and various retinoid compounds. TSH binds to the thyroid-stimulating hormone receptor (TSHR), which is cleaved into two subunits, A and B, and plays a major role in regulating thyroid function. The third cytoplasmic loop of TSHR has been identified as critical for its role in regulating inositol phosphate and cAMP formation. In Graves disease, an autoimmune disorder, TSHR is activated by autoantibodies, which may be stimulated by the cleavage of the A and B subunits.UniProt:
P16473Host:
MouseImmunogen:
Recombinant human TSHR beta chain protein was used as the immunogen for this TSH Receptor antibody.Clonality:
MonoclonalIsotype:
IgG2a κApplications:
IHC-PFormat:
PurifiedBuffer:
0.2 mg/ml in 1X PBS with 0.1 mg/ml BSA (US sourced) and 0.05% sodium azideReconstitution:
Store the TSH Receptor antibody at 2-8oC (with azide) or aliquot and store at -20oC or colder (without azide).Limitations:
This TSH Receptor antibody is available for research use only.CAS Number:
9007-83-4